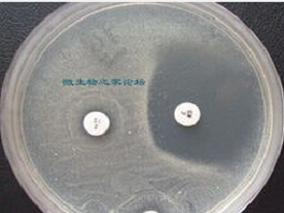
根除治疗后后续MRSA培养：3次培养足够吗？

-
IVIG治疗激素难治性皮肌炎的成本效用如何?
环球医学资讯
2015年05月20日
点击量:446
1小时条评论静脉注射免疫球蛋白(IVIg)是近年用于治疗重症皮肤病的一种方案。IVIG已被证明可有效治疗激素抵抗性皮肌炎(DM)。2015年5月,发表在《Pharmacoeconomics》上的一项研究显示,在泰国,IVIg联合糖皮质激素比免疫抑...
-
根除治疗后后续MRSA培养:3次培养足够吗?
环球医学资讯
2015年05月19日
点击量:573
1小时条评论抗药性金黄色葡萄球菌(简称MRSA)是金黄色葡萄球菌的一个独特菌株,能抵抗所有青霉素,包括甲氧西林及其他抗beta;内醘胺酶的青霉素。2015年5月,发表在《J Infect.》的一项研究比较了标准的3次MRSA后续培养与6次...
-
肺部感染情况影响口服左氧氟沙星上皮细胞渗透性
环球医学资讯
2015年05月19日
点击量:921
1小时条评论虽然上皮细胞衬液(ELF)为肺部感染的假想位点,但是多数的抗菌药渗透性研究都是在非感染的患者或健康志愿者中进行的。但2015年5月,发表在《Int J Antimicrob Agents》的一项研究表明,感染与否影响口服左氧氟沙...
-
维生素D补充不能降低活动性肺结核患者痰培养转化时间
环球医学资讯
2015年05月19日
点击量:413
1小时条评论活动性肺结核是指痰涂片阳性者,证明有结核分枝杆菌排出,病灶属于活动期。维生素D具有免疫调节的作用,能够辅助消除分枝杆菌的感染。2015年5月,发表在《Lancet Infect Dis》的一项随机、双盲、安慰剂对照、优效...
-
四环素类抗生素治疗多药耐药鲍氏不动杆菌感染效果如…
环球医学资讯
2015年05月19日
点击量:449
1小时条评论2015年5月,发表于《Int J Antimicrob Agents》的一篇文章对四环素类抗生素治疗鲍氏不动杆菌感染的临床证据进行了回顾。虽然包含四环素类抗生素的方案表现出了令人振奋的结果,但是需要更大型的比较试验中更多的...
-
DHHS对HIV指南更新了哪些内容?
环球医学资讯
2015年05月15日
点击量:810
1小时条评论4月8日,美国卫生与人类服务部(Department of Health and Human Services,DHHS)更新了HIV指南。 在何种药物开始部分,指南现在有5个推荐疗法。其中4个基于整合酶链转移抑制剂(INSTI)。它们包括: bull;Dol...
-
阿达木单抗维持治疗过程中阿达木单抗抗体与未来CD炎…
环球医学资讯
2015年05月15日
点击量:666
1小时条评论在2015年4月的《Gut》杂志中,一篇文章介绍了一项基于队列研究的均匀流动变化分析,目的在于探究阿达木单抗(ADL)用于治疗IBD患者的免疫原性数据。其结果为ATA和ADL与较高CRP水平和ADL终止具有紧密联系。 nbsp;...
-
他汀不能改善脓毒症患者的死亡率
环球医学资讯
2015年05月12日
点击量:252
1小时条评论基于观察性研究结果,他汀被推荐用于脓毒症的治疗。然而,随机对照试验没有证明他汀用于脓毒症治疗的收益。2015年4月,发表在《Am J Med》的一项研究对评价他汀类药物对脓毒症患者死亡率影响的随机试验进行了一项...
-
生殖支原体感染:阿奇霉素和替代抗生素治疗方案的有…
环球医学资讯
2015年05月12日
点击量:1372
1小时条评论生殖支原体是性传播疾病的病原体之一,与非淋菌性尿道炎及女性宫颈炎等疾病密切相关。目前治疗生殖支原体感染主要是阿奇霉素,但已经出现耐阿奇霉素的生殖支原体临床菌株的报道。2015年4月,发表在《Clin Infect ...
-
甲氧西林敏感金黄色葡萄球菌血流感染:经验性治疗vs…
环球医学资讯
2015年05月11日
点击量:553
1小时条评论2015年4月,发表于《Clin Infect Dis.》的一篇文章介绍了一项比较了beta;内酰胺和万古霉素经验治疗和明确治疗甲氧西林敏感金黄色葡萄球菌血流感染有效性的研究。结果显示,明确治疗上,beta;内酰胺类药物要优于万...

会员登录


网友评论
Yvette05-22
脱发一直是很多人的困扰,希望能广泛应用。
Ada305-22
补碘知识非常全面,获益匪浅。
penelope05-22
“盐重”问题确实需要重视